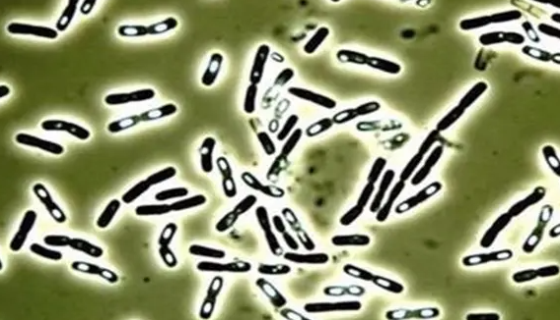
巨大芽孢杆菌的形态特征与生防特点及经济用途！

ATCC BAA-1953 甲酸甲烷杆菌 百欧博伟生物
甲酸甲烷杆菌,非模式菌株,主要用于产甲烷。

变形杆菌的分布区域与培养特性及抗原构造!
变形杆菌为能活泼运动而又极为多形性的一群肠道菌,有球形和丝状...
巨大芽孢杆菌的形态特征与生防特点及经济用途!
巨大芽孢杆菌为产孢杆菌,且为革兰氏阳性菌及好氧菌,也为常见的...

大鼠心肌细胞的原代培养及免疫荧光鉴定!
原代心肌细胞培养是体外研究心血管疾病相关机制的主要手段和基本...

嗜酸乳杆菌的培养特性与获取方式及健康作用!
嗜酸乳杆菌又称A菌,是乳杆菌属的一种。有助于消化系统将糖分解...

小牛肉葡萄球菌冷冻干燥保藏转接技术与方法!
小牛肉葡萄球菌,仅用于科学研究或者工业应用等非医疗目的不可用...

ATCC 18450 灰盖鬼伞的特点与优势及培养!
灰盖鬼伞(Coprinopsis cinerea)是小脆柄菇...

溶藻弧菌——用于分析检测和质量控制
溶藻弧菌是Vibrio属的微生物,原产地为中国。非模式菌株。...

啤酒酵母的性质与用途及生产工艺!
啤酒酵母是酿酒过程中培育出来的,含有非常丰富的营养物质,包括...